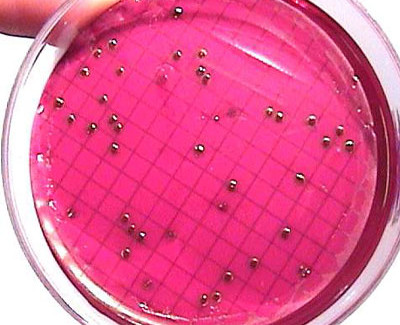

Coliform Bacteria
All natural waters, whether from surface or shallow ground sources, are contaminated to some degree with bacteria. Generally, these bacteria are harmless to humans and essential to the breakdown of natural organic materials found in the water; however, when a water source is polluted by human or animal wastes, the water may contain microbiological organisms that can cause illness. These bacteria are difficult and time consuming to isolate and identify, so microbiologists have developed the "total coliform test" to simplify the task. Coliform bacteria are widely distributed in nature and are also found in the large intestine of humans and animals. Their presence in a water supply is used as an "indicator" of possible pollution which may contain disease-causing organisms. The total coliform group can survive longer in water than most disease-causing organisms and are easier to identify. The absence of total coliform is, therefore, considered evidence of bacteriologically safe water.
Many violations of the total coliform bacteria standards have resulted from inadequate disinfection after construction or maintenance work. After replacing or repairing a pump in an existing well, for example, the well water will often be temporarily contaminated with coliform bacteria, which are present in soil, vegetation and the tools and hands of the maintenance crew.
Since dirt and accompanying bacteria almost always enter the well during maintenance activities, the entire system should be flushed out, disinfected and sampled for coliforms prior to being put back into service. This is referred to as "shock chlorination" of the well. See the domestic well information --> chlorination of wells.